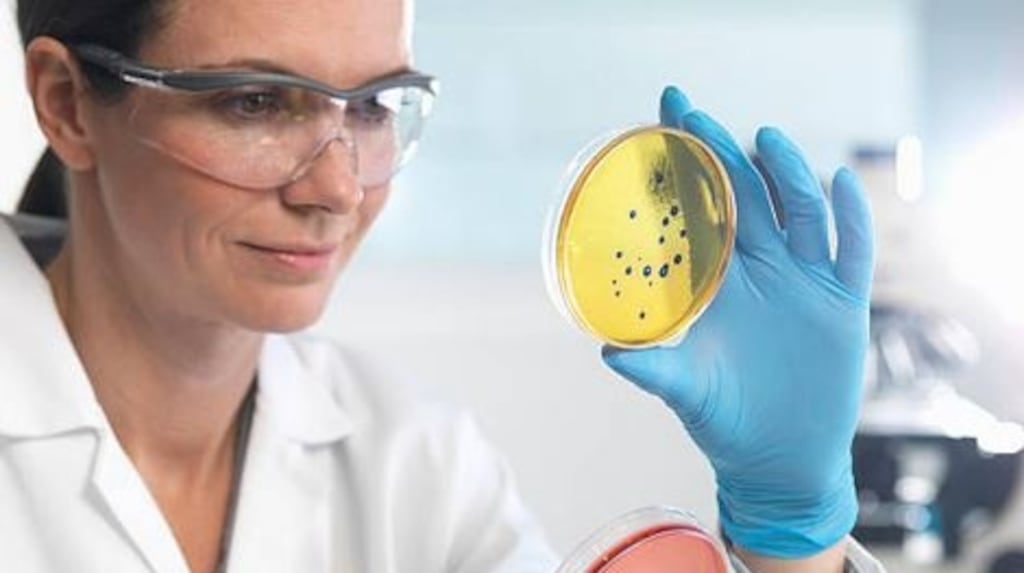
All age groups are affected by infections with antibiotic-resistant bacteria, although their burden is significantly higher among infants than in any other age group. Photograph: Getty Images

Antibiotic-resistant superbugs cause an average 5,000 infections and 219 deaths in Ireland each year, according to a new report.
Ireland ranks 14th out of 31 countries for the burden imposed by five of the most common antibiotic-resistant bacteria across Europe, the research published in The Lancet Infectious Diseases journal finds.
The study estimates that about 33,000 people die in Europe each year as a direct consequence of an infection caused by bacteria resistant to antibiotics. The burden of these infections – measured in terms of cases, deaths and disablement caused by the superbugs – is comparable to that of influenza, tuberculosis and HIV/Aids combined.
Some 75 per cent of the burden of disease is due to healthcare-associated infections, according to the study. Reducing this through adequate infection prevention and control measures, as well as stewarding the use of antibiotics, could be an achievable goal in healthcare settings, it suggests.
The role played by antibiotic-resistant bacteria to overall health burdens varies greatly between different countries, with Italy alone accounting for one-third of all cases in Europe.
Of particular concern is a finding that 39 per cent of the burden is caused by infections with bacteria resistant to last-line antibiotics such as carbapenems and colistin.
“This is an increase from 2007, and is worrying because these antibiotics are the last treatment options available. When these are no longer effective it is extremely difficult or, in many cases, impossible to treat infections.”
Age groups
The study shows all age groups are affected by infections with antibiotic-resistant bacteria, although their burden is significantly higher among infants than in any other age group. Among adults, the burden increases with age, suggesting that the ageing EU and EEA population will pose an increasing challenge in the future.
In adults and young adults a higher proportion of the burden was caused by infections with carbapenem-resistant and colistin-resistant bacteria.
The study notes that in Ireland two vancomycin-resistant gut bugs, E faecalis and E faecium, caused a higher proportion of the total burden than in other countries.
Rising resistance to antibiotics globally has been blamed on their overuse, particularly on animals.